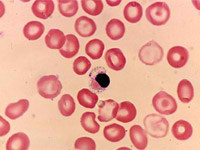

|
Descubren técnica para detectar enfermedades en fetos, sin riesgo para el bebé
 Lunes, 20/12/2010 - 19:17
Lunes, 20/12/2010 - 19:17
Un grupo de cientÃficos logró secuenciar el ADN de un feto a través de una muestra de sangre de la madre, con una novedosa técnica que ayudará a detectar enfermedades genéticas sin necesidad de poner en peligro al bebé ni a la madre.
Leer más...
|
|
El ADN identifica uno de los pájaros más raros del mundo
 Jueves, 9/12/2010 - 19:15
Jueves, 9/12/2010 - 19:15
Un equipo de investigadores australianos en el que participaron expertos de ADN de la Universidad de Adelaida ha identificado una nueva especie de loro de tierra en el oeste de la isla continente, en peligro crÃtico de extinción.
Leer más...
|
|
Gen del autismo genera conexiones distintas en el cerebro, según investigadores
 Sábado, 13/11/2010 - 11:30
Sábado, 13/11/2010 - 11:30
Una cantidad excesiva de conexiones en el lóbulo frontal del cerebro explicarÃa algunos de los problemas de aprendizaje que sufren las personas autistas, informaron investigadores estadounidenses.
Leer más...
|
|
La genética determina los sentimientos y el comportamiento de los humanos
 Sábado, 13/11/2010 - 6:38
Sábado, 13/11/2010 - 6:38
La genética determina no sólo la estructura fÃsica sino también la intimidad humana, es decir, el comportamiento, los sentimientos, la respuesta de las personas a los estÃmulos, explica el investigador Ginés Morata, Premio PrÃncipe de Asturias de Investigación CientÃfica y Técnica en 2007.
Leer más...
|
|
Descubren los genes responsables de los cuerpos con forma de pera o manzana
 Jueves, 11/11/2010 - 21:32
Jueves, 11/11/2010 - 21:32
Los cientÃficos comprobaron que algunos de los nuevos hallazgos sugieren una participación activa de los genes en las zonas cerebrales que influyen en el apetito, mientras otros indican que los genes están involucrados en el control de la insulina y las funciones metabólicas.
Leer más...
|
|
Ya hay excusa: la envidia está en los genes
 Jueves, 11/11/2010 - 12:56
Jueves, 11/11/2010 - 12:56
Hay 'poderosas razones evolutivas' para que las personas sean envidiosas por naturaleza, ya que se trata de un sentimiento 'codificado en los genes' humanos, según el catedrático del Departamento de EconomÃa de la Universidad Carlos III de Madrid (UC3M) Antonio Cabrales.
Leer más...
|
|
Cada persona tiene 75 errores relacionados con enfermedades hereditarias en sus genes
 Viernes, 5/11/2010 - 22:2
Viernes, 5/11/2010 - 22:2
Aunque se sabe que algunos desórdenes -obesidad, diabetes o enfermedad cardiovascular- tienen un fuerte componente genético, las variantes genómicas detectadas no pueden explicar la mayor parte de los efectos vistos en las familias afectadas.
Leer más...
|
|
Argentina clona al primer animal en Latinoamérica
 Lunes, 25/10/2010 - 13:7
Lunes, 25/10/2010 - 13:7
El laboratorio argentino Bio Sidus anunció que logró la primera clonación de un caballo en América Latina a partir de células de la piel de otro ejemplar de la raza Ñandubay, con el fin de otorgar capacidad reproductiva a estos equinos utilizados en pruebas deportivas, como el polo y el salto.
Leer más...
|
|
Recuperan el ADN de Luis XVI, en una calabaza
 Martes, 19/10/2010 - 15:37
Martes, 19/10/2010 - 15:37
CientÃficos del CSIC han analizado el ADN conservado en una calabaza. Un testigo de la ejecución mojó su pañuelo en sangre y lo guardó en ella. Luego la mandó decorar y ahora vale 2 millones de euros.
Leer más...
|
|
Identifican variantes genéticas asociadas a la obesidad
 Lunes, 18/10/2010 - 8:41
Lunes, 18/10/2010 - 8:41
Dos estudios independientes de investigadores en el Reino Unido y Alemania han identificado variantes asociadas con caracterÃsticas relacionadas con la obesidad. Sus resultados se publican en la edición digital de la revista 'Nature Genetics'.
Leer más...
|
|
Descubren genes relacionados con la estatura
 Lunes, 4/10/2010 - 15:5
Lunes, 4/10/2010 - 15:5
CientÃficos hallaron hasta 180 variaciones genéticas que demuestra que no hay un único gen que define la altura de una persona. Las variaciones genéticas descubiertas apenas podrÃan explicar el 10% de la altura final de alguien.
Leer más...
|
|
Científicos hallaron gen para tratar enfermedades del sistema nervioso
 Sábado, 2/10/2010 - 13:54
Sábado, 2/10/2010 - 13:54
En un estudio, publicado en la revista 'Nature Neuroscience', expertos británicos hallaron que un gen, llamado Sox9, clave para el desarrollo de las células madre neurales en el embrión humano, que son las que luego se convierten en tejido cerebral o espinal.
Leer más...
|
|
Descubren microRNAs capaces de modular la respuesta de células ante estímulos proliferativos
 Martes, 21/9/2010 - 14:55
Martes, 21/9/2010 - 14:55
Investigadores de la Universidad Autónoma de Madrid (UAM) y de la Universidad del PaÃs Vasco (UPV) han descubierto un grupo de microRNAs capaces de modular la respuesta de las células ante estÃmulos proliferativos, según los resultados que han publicado en la revista 'Molecular and cellular Biology'.
Leer más...
|
|
Científicos curan extraña clase de anemia con manipulación genética
Sábado, 18/9/2010 - 22:49
Sábado, 18/9/2010 - 22:49
Un paciente con una forma genética extraña de anemia está superando el problema sin necesidad de transfusiones de sangre después de una terapia experimental con genes, informaron investigadores franceses y estadounidenses.
Leer más...
|
|
7 |







